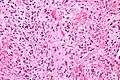
Solitary fibrous tumor - high magnification. H&E stain.

Solitary fibrous tumor
| Solitary fibrous tumor | |
|---|---|
| Other names | Fibrous tumor of the pleura |
 | |
| Micrograph of a solitary fibrous tumor. H&E stain. | |
| Specialty | Oncology |
Solitary fibrous tumor (SFT), also known as fibrous tumor of the pleura, is a rare mesenchymal tumor originating in the pleura[1] or at virtually any site in the soft tissue including the seminal vesicle.[2] Approximately 78% to 88% of SFT's are benign and 12% to 22% are malignant.[3] The World Health Organization (2020) classified SFT as a specific type of tumor in the category of malignant fibroblastic and myofibroblastic tumors.[4]
Signs and symptoms
About 80% of pleural SFTs originate in the visceral pleura, while 20% arise from parietal pleura. Although they are often very large tumors—up to 40 centimetres (16 in) in diameter—over half are asymptomatic at diagnosis.[5] While some researchers have proposed that a SFT occupying at least 40% of the affected hemithorax be considered a "giant solitary fibrous tumor",[6] no such "giant" variant has yet been recognized within the most widely used pleural tumor classification scheme.[1]
Pathophysiology
Recurrent somatic fusions of the two genes, NGFI-A–binding protein 2 (NAB2) and STAT6, located at chromosomal region 12q13, have been identified in solitary fibrous tumors.[7]


Treatment
The treatment of choice for both benign and malignant SFT is complete en bloc surgical resection.
Prognosis
Prognosis in benign SFTs is excellent. About 8% will recur after first resection, with the recurrence usually cured after additional surgery.[3]
The prognosis in malignant SFTs is much more guarded. Approximately 63% of patients will have a recurrence of their tumor, of which more than half will succumb to disease progression within two years.[3] Adjuvant chemotherapy and/or radiotherapy in malignant SFT remains controversial.[3]
History
SFT was first mentioned in the scientific literature by Wagner.[8] The first discussion of its clinical and pathological properties was by Klemperer and Rabin.[3][9] SFTs have also been known as hemangiopericytomas although this term has now been discontinued from WHO tumor classifications.
Over the years pleural SFTs acquired a number of synonyms, including localized fibrous tumor, benign mesothelioma, localized fibrous mesothelioma, submesothelial fibroma, and pleural fibroma. The use of names that include mesothelioma for this tumor is discouraged because of potential confusion with diffuse malignant mesothelioma, a much more serious disease.[1]
See also
Additional images
-
 Gross pathology of an atypical solitary fibrous tumor, evidenced by some deeply yellow necrotic areas
Gross pathology of an atypical solitary fibrous tumor, evidenced by some deeply yellow necrotic areas -
 Solitary fibrous tumor - low magnification. H&E stain.
Solitary fibrous tumor - low magnification. H&E stain. -
Solitary fibrous tumor - high magnification. H&E stain.
Solitary fibrous tumor - high magnification. H&E stain.
References
- ^ a b c Travis WD, Brambilla E, Muller-Hermelink HK, Harris CC (Eds.): World Health Organization Classification of Tumours. Pathology and Genetics of Tumours of the Lung, Pleura, Thymus and Heart. IARC Press: Lyon 2004.
- ^ Khandelwal, Ashish; Virmani, Vivek; Amin, Md. Shahrier; George, Uttam; Khandelwal, Kanika; Gorsi, Ujjwal (2013). "Radiology–pathology conference: malignant solitary fibrous tumor of the seminal vesicle". Clinical Imaging. 37 (2): 409–413. doi:10.1016/j.clinimag.2012.04.027. PMID 23466005.
- ^ a b c d e Robinson LA. Solitary fibrous tumor of the pleura. Cancer Control 2006;13:264-9.
- ^ Sbaraglia M, Bellan E, Dei Tos AP (April 2021). "The 2020 WHO Classification of Soft Tissue Tumours: news and perspectives". Pathologica. 113 (2): 70–84. doi:10.32074/1591-951X-213. PMC 8167394. PMID 33179614.
- ^ Briselli M, Mark EJ, Dickersin GR. Solitary fibrous tumors of the pleura: eight new cases and review of 360 cases in the literature" Cancer 1981;47:2678-89.
- ^ Pinedo-Onofre JA, Robles-Pérez E, Peña-Mirabal ES, Hernández-Carrillo JA, Téllez-Becerra JL. [Giant solitary fibrous tumor of the pleura.] Cir Cir 2010;78:31-43. [Article in Spanish].
- ^ Tai, HC., Chuang, IC., Chen, TC. et al. NAB2–STAT6 fusion types account for clinicopathological variations in solitary fibrous tumors. Mod Pathol 28, 1324–1335 (2015). https://doi.org/10.1038/modpathol.2015.90
- ^ Wagner E. Das tuberkelahnliche lymphadenom (der cytogene oder reticulirte tuberkel). Arch Heilk (Leipig). 1870;11:497.>
- ^ de Perrot M, Fischer S, Brundler MA, et al. Solitary fibrous tumors of the pleura. Ann Thorac Surg. 2002;74:285-293.